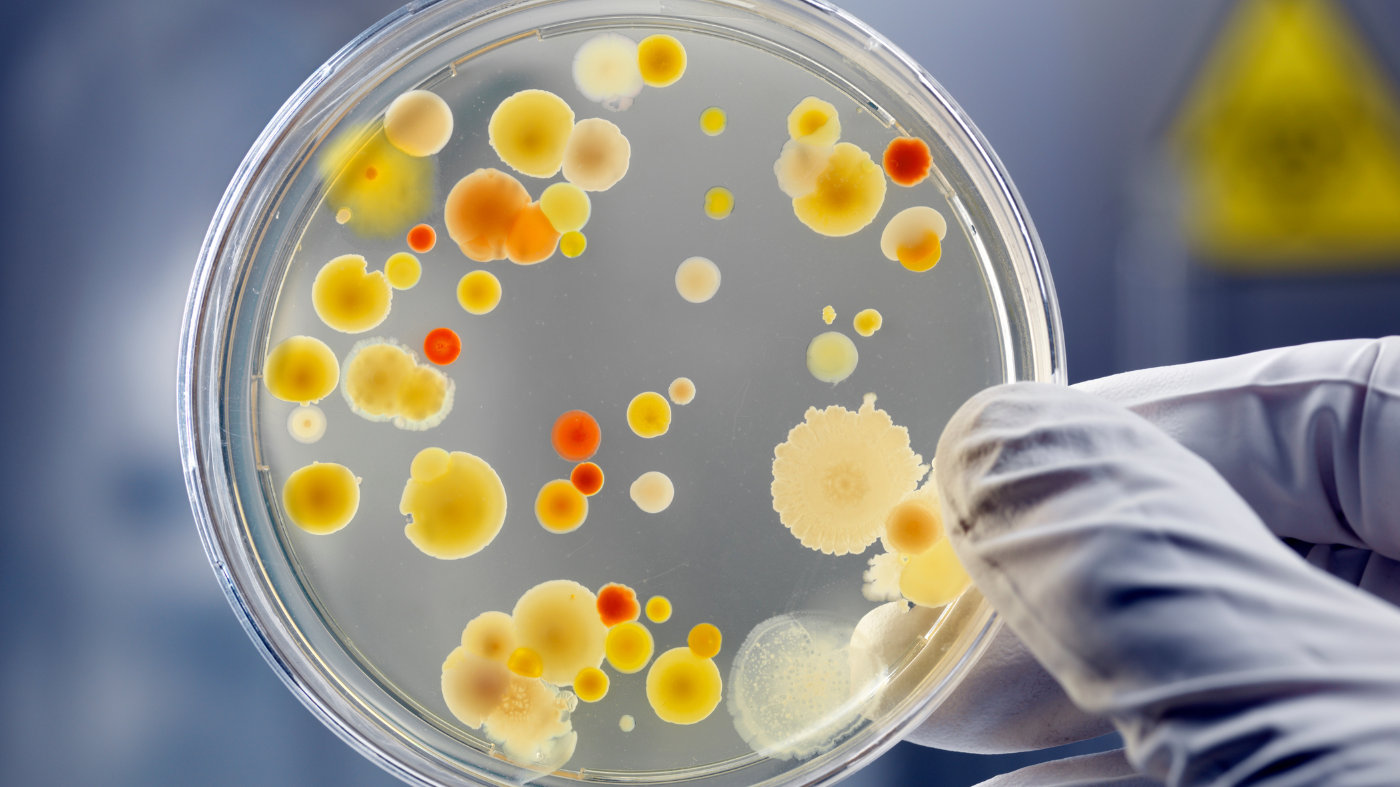
a gloved hand holding a petri dish with bacteria culture

The Department of Chemical Engineering and Materials Science provides a technology-centric research environment in several key and emerging areas to address significant problems of our time.
Our faculty engage students to conduct cutting-edge and impactful research in chemical engineering and materials science with applications in important areas like sustainability and healthcare.
Our award-winning researchers have been awarded numerous grants from prominent agencies such as the National Science Foundation (NSF), the Department of Energy (DOE), the National Institute of Health (NIH), the Department of Defense (DOD), The National Aeronautics and Space Administration (NASA), American Chemical Society (ACS), Janssen, Samsung, LG and many others.
The department is home to various centers and laboratories, including the Highly Filled Materials Institute, the Soft Materials Laboratory, the Laboratory for Multi-Scale Imaging, the New Jersey Center for Microchemical Systems, the Nano-Micro-Bio Laboratory and the Micro-Nano Solutions for Alternative Energy Laboratory.
Graduate Studies: Flexible, Supported, Connected
Stevens’ graduate programs in Chemical Engineering and Materials Science empower you to build a sustainable, globally relevant career. You’ll collaborate with experts on research that spans areas like nanomaterials, alternative energy and sustainable systems, and develop problem-solving skills that evolve with the field. Located right across the river from New York City, Stevens also connects you with industry leaders and a thriving alumni network to support your next step—whether in academia, research, or the private sector.